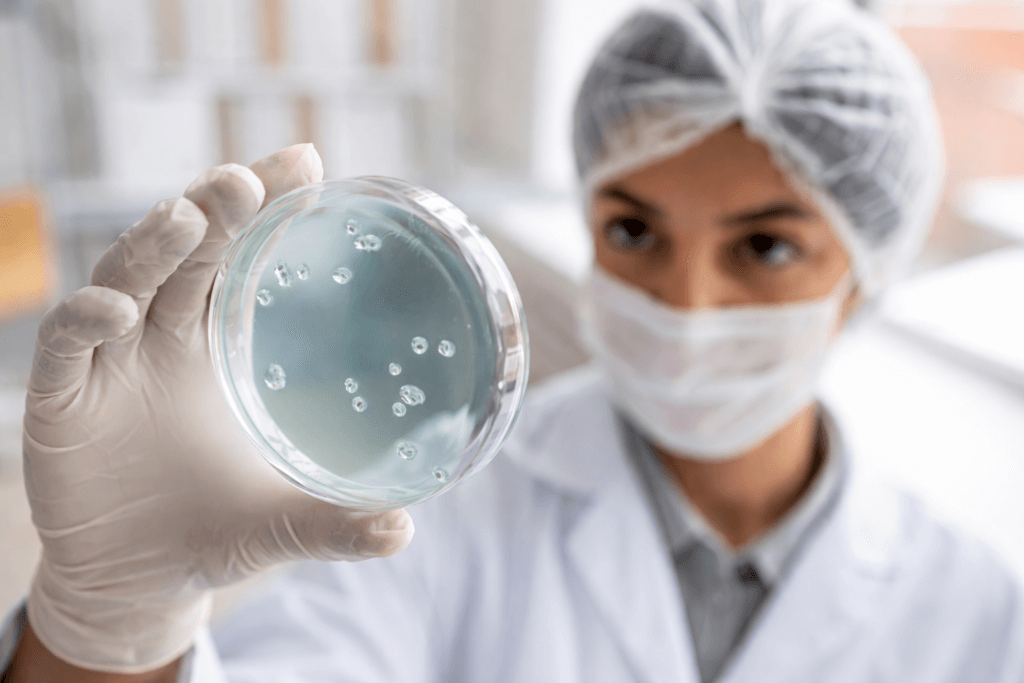

FDA aprova antibiótico ceftobiprol da Basilea
Novo antibiótico amplia opções contra infecções resistentes A FDA aprovou o antibiótico ceftobiprol, desenvolvido pela Basilea Pharmaceutica, para o tratamento de infecções bacterianas, incluindo cepas multirresistentes. A decisão amplia as alternativas terapêuticas nos Estados Unidos diante do avanço das infecções resistentes a antimicrobianos. O medicamento intravenoso será comercializado sob a marca Zevtera no mercado norte-americano. […]